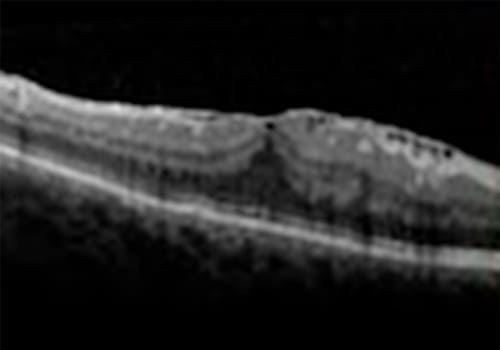

O que é Membrana Epiretiniana (MER)

A membrana epirretiniana (MER) é uma condição ocular na qual se forma uma fina camada de tecido fibroso na superfície da retina, especificamente na região da mácula.
Essa membrana fibrosa pode se formar devido a várias razões, sendo a mais comum a contração do vítreo posterior, que é o gel transparente que preenche o interior do olho. À medida que o vítreo se contrai e se separa da retina, pode ocorrer uma tração na superfície da retina, resultando na formação da membrana epirretiniana.
Quais são os sintomas?
Os sintomas podem variar, dependendo da gravidade e da localização da membrana, mas geralmente incluem:
•Visão borrada ou embaçada, especialmente na visão central
•Distorção da imagem, com linhas retas parecendo curvas ou onduladas
•Dificuldade em ler ou reconhecer rostos
Como é realizado do diagnóstico?
Com exames realizados por oftalmologista especialista em retina, incluindo:
•Mapeamento de retina (fundo de olho)
•Retinografia colorida
•Tomografia de coerência óptica (OCT)
Qual o tratamento?
Em muitos casos, a membrana epiretiniana é assintomática ou causa apenas sintomas leves, não requerendo tratamento específico. No entanto, em casos em que os sintomas são significativos e interferem nas atividades diárias, pode ser considerada a opção de cirurgia para remover a membrana. A cirurgia é conhecida como vitrectomia com remoção da membrana epiretiniana e pode ajudar a melhorar a visão e reduzir os sintomas.







